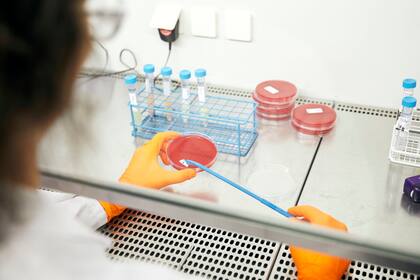
Los investigadores demostraron que estas células pueden actuar como marcadores del riesgo de enfermedades hematológicas

Con un simple análisis de sangre logran detectar un cáncer en alza y evitar así el viejo método invasivo
Investigadores del Instituto Weizmann identificaron marcadores genéticos en células madre circulantes que permiten anticipar el desarrollo de leucemia mieloide aguda
5 minutos de lectura'

Científicos del Instituto Weizmann de Ciencias, en Israel, desarrollaron una novedosa prueba de sangre que podría cambiar radicalmente la forma en que se diagnostica la leucemia.
Este avance, publicado recientemente en la revista Nature Medicine, permitiría reemplazar la tradicional y dolorosa punción lumbar —necesaria hasta ahora para obtener una muestra de médula ósea— por un análisis mucho más sencillo y menos invasivo.
Los responsables de este trabajo son los profesores Liran Shlush y Amos Tanay, quienes llevan años estudiando cómo la sangre refleja el proceso de envejecimiento y puede anticipar la aparición de distintas enfermedades.
Sus investigaciones se centran en comprender por qué, a medida que envejecen, algunas personas se vuelven más propensas a desarrollar patologías graves. Para ello, junto a un equipo multidisciplinario de médicos, biólogos y especialistas en ciencia de datos, analizan mutaciones que aparecen con la edad en las células madre hematopoyéticas, que son las encargadas de producir todas las células de la sangre.
Estas alteraciones genéticas, frecuentes en personas mayores de 40 años, no solo se asocian a cánceres hematológicos como la leucemia, sino también a enfermedades cardiovasculares, diabetes y otros trastornos vinculados al envejecimiento.
De hecho, investigaciones previas ya habían demostrado que ciertas mutaciones en estas células madre pueden anticipar el desarrollo de leucemia mieloide aguda (LMA), un tipo de cáncer que suele aparecer de manera repentina, sin síntomas previos evidentes, y que afecta principalmente a mayores de 65 años.
En estos casos, la mortalidad supera el 90%. Aunque estas mutaciones también pueden darse en personas sanas —en un fenómeno conocido como hematopoyesis clonal relacionada con la edad (ARCH, por sus siglas en inglés)— no siempre progresan a una enfermedad. Por eso, uno de los grandes desafíos ha sido distinguir entre una forma benigna de ARCH y un riesgo real de desarrollar LMA.
Para enfrentar ese desafío, investigadores recurrieron a la secuenciación genética profunda, analizando genes comúnmente alterados en la LMA. Compararon muestras de sangre de 95 personas que luego desarrollaron la enfermedad (en promedio, seis años después) con las de 414 individuos sanos, emparejados por edad y género. Encontraron diferencias significativas: los futuros pacientes presentaban más mutaciones, con mayor frecuencia alélica y afectando genes clave asociados a la leucemia.
Con esta información, diseñaron un modelo genético capaz de predecir el riesgo de desarrollar LMA, que fue validado en otra cohorte independiente y luego adaptado a gran escala utilizando bases de datos de historias clínicas electrónicas. El estudio prueba que es posible detectar años antes quién tiene más probabilidad de desarrollar esta forma de cáncer, lo que podría allanar el camino para un diagnóstico temprano, un seguimiento más eficaz y, eventualmente, intervenciones preventivas.
En paralelo, los investigadores del Weizmann se enfocaron específicamente en el síndrome mielodisplásico (MDS), una condición asociada a la edad en la que las células madre sanguíneas no logran madurar en células funcionales. Esta afección puede causar anemia severa y progresar a LMA. Según el Estudio de Carga Global de Enfermedad, su incidencia aumentó un 35% en varones y un 8% en mujeres en los últimos veinte años. El diagnóstico de MDS, al igual que el de la leucemia, requería hasta ahora una muestra de médula ósea.
Pero el nuevo trabajo demostró que una simple extracción de sangre puede proporcionar información clave. El equipo de investigación liderado por Nili Furer, Nimrod Rappoport y Oren Milman, en colaboración con colegas de Israel y Estados Unidos, logró identificar en la sangre células madre hematopoyéticas circulantes (cHSPCs) que contienen datos diagnósticos relevantes. Estas células, que ocasionalmente escapan de la médula al torrente sanguíneo, fueron analizadas mediante tecnologías de secuenciación a nivel de célula individual.
En el análisis de muestras de 148 personas sanas, descubrieron que si bien hay una gran variabilidad en la composición de tipos celulares entre individuos, los estados funcionales de esas células son notablemente estables y comparables. Además, observaron que las cHSPCs presentes en sangre son similares a las de la médula ósea, aunque con una tasa de división algo menor, lo que las convierte en una alternativa prometedora para el estudio de enfermedades hematológicas sin procedimientos invasivos.
Otro hallazgo clave fue que estas células pueden comportarse como una especie de reloj biológico: su comportamiento y evolución reflejan la edad biológica más que la cronológica. También vieron que el envejecimiento celular se acelera más en hombres que en mujeres, lo que podría explicar la mayor prevalencia de leucemia y otros cánceres hematológicos en la población masculina.
Para los investigadores, esta prueba de sangre para diagnosticar MDS y LMA es solo el comienzo. Creen que podría adaptarse en el futuro para detectar otros trastornos vinculados con la sangre. Actualmente, los hallazgos ya se están evaluando en un ensayo clínico internacional de gran escala, con participación de varios centros médicos del mundo.





